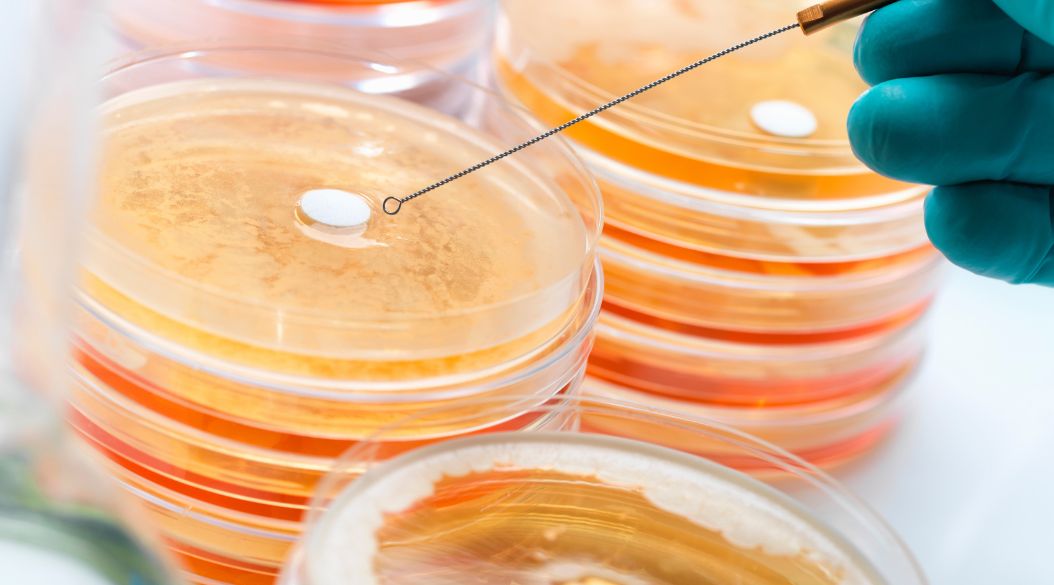
bacterias resistentes a los antibioticos

El Grupo de Líderes Mundiales sobre la Resistencia a los Antimicrobianos (RAM ) ha publicado un informe que advierte sobre las graves consecuencias de la inacción frente a este problema creciente.
El estudio económico presentado por el grupo confirma que la resistencia a los antimicrobianos no solo tiene un costo humano significativo, sino que también representa una amenaza considerable para la economía global.
El informe destaca que la resistencia a los antimicrobianos ya es responsable de 1,27 millones de muertes al año, una de cada cinco en niños menores de cinco años.
Advierte además que si no se toman medidas contundentes, la esperanza de vida podría reducirse en 1,8 años para 2035.
Revela también que el impacto económico sería de 412.000 millones de dólares anuales en costos sanitarios y 443.000 millones de dólares en pérdida de productividad.
Ante este panorama el GLG insta a los Estados miembros de la ONU a tomar medidas audaces y específicas para abordar la RAM.
El informe propone una serie de recomendaciones, incluyendo: asegurar financiación adecuada, predecible y sostenible para combatir la RAM, implementar estrategias de prevención de infecciones en la salud humana, animal y en los ecosistemas, reducir el consumo de antimicrobianos en un 30% a 50% en el sector agroalimentario y eliminar el uso de antimicrobianos de importancia médica en animales para fines no veterinarios.
El GLG propone objetivos tangibles para 2030, como: reducir en un 10% las muertes por RAM a nivel mundial, asegurar que el 80% del consumo de antibióticos en humanos sean del grupo ACCESS y eliminar el uso de antimicrobianos de importancia médica en animales para fines no veterinarios.
“Tenemos las herramientas para mitigar la crisis de la RAM y estos datos apuntan a un futuro devastador si no tomamos medidas más audaces ahora” , dice la Presidenta del GLG sobre la RAM, Mia Amor Mottley, Primera Ministra de Barbados. “Es por eso que el Grupo de Líderes Globales está haciendo recomendaciones y proponiendo objetivos para impulsar una respuesta global sólida a la RAM y salvar millones de vidas».